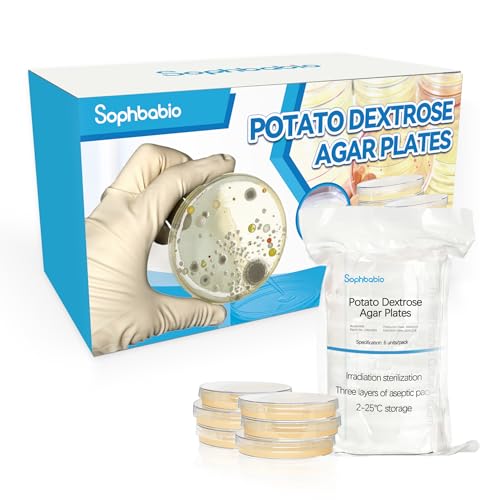
Potato Dextrose Agar(PDA) Plates for Mushroom Cultivation, Mold Detection 6 Pack, and Science Projects...
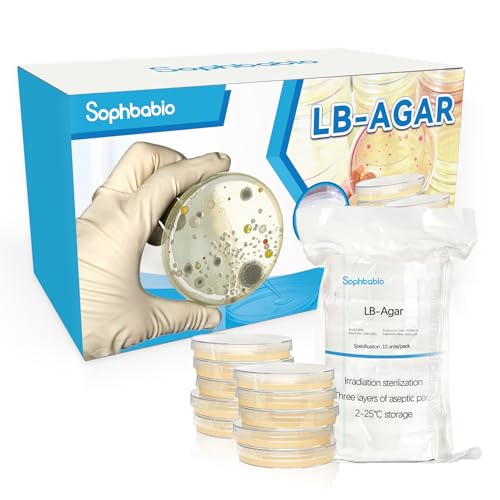
LB Agar Plates – 10 Pre-Poured Sterile Petri Dishes + 15 Sterile Swabs – Fresh, Triple-Sealed for...

Agar media and plates are fundamental tools in microbiology, essential for cultivating and identifying a vast array of microorganisms. Selecting the appropriate type is crucial for accurate research, reliable diagnostics, and successful industrial applications, ensuring reproducible results and preventing contamination.
Looking for the best Life Science Agar Media & Plates?
Discover now our comparison of the best Life Science Agar Media & Plates. It is never easy to choose from the wide range of offers. On the market, you will find an incalculable number of models, all at different prices. And as you will discover, the best Life Science Agar Media & Plates are not always the ones at the highest prices! Many criteria are used, and they make the richness and relevance of this comparison.
To help you make the best choice among the hundreds of products available, we have decided to offer you a comparison of the Life Science Agar Media & Plates in order to find the best quality/price ratio. In this ranking, you will find products listed according to their price, but also their characteristics and the opinions of other customers. Also discover our comparisons by categories. You won’t have to choose your products at random anymore.
- BIOTECH QUALITY, FRESH AND READY-TO-USE: Factory-direct fresh 10 100-mm Pre-poured sterile LB-agar plates and 10 sterile 6-inch long swabs (in 5 pouches). Our plates are manufactured in USA using the biotech GMP standards. Each plate has a fresh and thick...
- The Safest Agar Plates On Amazon: Luria Broth(LB) agar plates are used to detect environmental microorganisms all over the world. They are the safest agar plates to be used by students in the classroom or at home.
- Free Science Fair Project E-Book: Packed with easy-to-do science fair experiments with clear step-by-step instructions to help you win a science fair competition. These experiments are scientifically designed and tested to ensure your success. Tips and...
- PEACE OF MIND: Any questions? No worry. Inside the kit you will find a toll-free number that you can call in case you have a question about the product. You will receive immediate live support from PhD scientists with extensive hands-on experience. Before...
- 🐯 OUR DIFFERENCES: iigala's products are individually sealed. With each plate & cotton swab having a separate sealed packaging. This way, you can open a certain plate according to your own arrangement, while other plates are completely unaffected...
- 🦁 THE COMPLETE SCIENCE KIT: Start your science experiment journey with our kit, complete with 10 pre-poured agar plates, 10 cotton tipped sticks, 2 pipette, 2 plastic vial to be used in experiments, 1 user's manual.
- 🦊 SCIENCE EXPERIMENTS PROJECT TOOLS: This petri dish with agar is a great agar choice for science fair and classroom projects, Extract Agar can be used for science fair projects or classroom experiments because it cultures a wide variety of and is safe...
- 🐮 DIY MOLD TESTING: You can use it to detect mold in your home. For example, you can use it to detect areas such as rooms, HVAC pipes, walls, and dark and damp places that are prone to mold growth. Because these molds may cause symptoms such as...
- 🐶 PURCHASE TIPS: Due to changes in temperature, condensation may occur in the dish, which is a normal phenomenon and does not affect the use of the product. If the agar you receive is melted, please put the refrigerator for half an hour before using...
- THE COMPLETE SCIENCE KIT: Start your science experiment journey with our kit, complete with 10 pre-poured agar plates, 10 cotton tipped sticks, 1 pipette, 1 plastic vial to be used in experiments, simple-to-follow instructions, and an informative science...
- RELIABLE & SECURE: Experience the height of science education with our kit, created for educational purposes. These agar plates include a thick agar layer, that are ready to use for your experiment. The customized packaging are more durable than...
- CONVENIENTLY PRE-POURED FOR EASY USE: Our pre-poured, ready-to-use nutrient agar petri dishes eliminates the need for technical agar melting and pouring. Our skillfully concocted plates facilitates proper agar consistency and thickness.
- THE EXPERIMENT EBOOK: Get creative and think of thrilling ideas to experiment in the classroom with our science kit that includes an exciting experiment ebook. The eBook is filled with simple experiments that come with clear step-by-step instructions to...
- WE VALUE CUSTOMER SATISFACTION: We believe that you will enjoy your science fair project kit and would even suggest it to your acquaintances. However, if you are not entirely satisfied with it, please let us know and we will make things right.
- BIOTECH QUALITY, FRESH AND READY-TO-USE: Factory-direct fresh 10 100-mm Pre-poured sterile LB-agar plates and 10 sterile 6-inch long swabs (in 5 pouches). Our plates are manufactured in USA using the biotech GMP standards. Each plate has a fresh and thick...
- The Safest Agar Plates On Amazon: Luria Broth(LB) agar plates are used to detect environmental microorganisms all over the world. They are the safest agar plates to be used by students in the classroom or at home.
- Free Science Fair Project E-Book: Packed with easy-to-do science fair experiments with clear step-by-step instructions to help you win a science fair competition. These experiments are scientifically designed and tested to ensure your success. Tips and...
- PEACE OF MIND: Any questions? No worry. Inside the kit you will find a toll-free number that you can call in case you have a question about the product. You will receive immediate live support from PhD scientists with extensive hands-on experience. Before...
- SAFE IS OUR PRIORITY - Our plates are sterilized using biotech industry standards. They are proved to be safe for kids.
- BIOTECH QUALITY, FRESH AND READY-TO-USE: Factory-direct fresh 10 100-mm Pre-poured sterile LB-agar plates and 10 sterile 6-inch long swabs (in 5 pouches). Our plates are manufactured using the biotech GMP standards. Each plate has a fresh and thick layer...
- COMPLETE SCIENCE KIT - The AGAR PLATES kit contains everything you need to carry out the science experience. Each kit includes 10 pre-poured agar plates, 10 sterile cotton swabs, 2 plastic droppers, and a easy to follow science experiment project guide.
- CONVENIENT, PRE-POURED PLATES. Our plates are ready-to-use. No need to prepare the plates yourself.
- WE VALUE CUSTOMER SATISFACTION: We believe that you will enjoy your science fair project kit and would even suggest it to your acquaintances. However, if you are not entirely satisfied with it, please let us know and we will make things right.
- 🐯 OUR DIFFERENCES: anlab's products are individually sealed. With each plate & cotton swab having a separate sealed packaging. This way, you can open a certain plate according to your own arrangement, while other plates are completely unaffected. Other...
- 🦁 THE COMPLETE SCIENCE KIT: Start your science experiment journey with our kit, complete with 10 pre-poured agar plates, 10 cotton tipped sticks, 2 pipette, 2 plastic vial to be used in experiments, 1 user's manual.
- 🦊 SCIENCE EXPERIMENTS PROJECT TOOLS: This petri dish with agar is a great agar choice for science fair and classroom projects, Extract Agar can be used for science fair projects or classroom experiments because it cultures a wide variety of and is safe...
- 🐮 DIY MOLD TESTING: You can use it to detect mold in your home. For example, you can use it to detect areas such as rooms, HVAC pipes, walls, and dark and damp places that are prone to mold growth. Because these molds may cause symptoms such as...
- 🐶 PURCHASE TIPS: Due to changes in temperature, condensation may occur in the dish, which is a normal phenomenon and does not affect the use of the product. If the agar you receive is melted, please put the refrigerator for half an hour before using...
- GENERAL PURPOSE GROWTH MEDIUM || 200 ml bottle of prepared growth medium. Used to grow, maintain, and study a wide variety of bacteria and some fungi in petri dishes or culture tube slants.
- EASY TO PREPARE || Simply heat bottle until all the medium is liquified. Pour into petri dishes or culture tubes, then allow medium to cool and harden.
- EXCELLENT FOR LABORATORIES AND CLASSROOMS || Ideal for use in general biology and microbiology laboratories and classrooms.
- APPLICATIONS || Nutrient Agar will allow a wide variety of bacteria and some fungi to grow, so it is great for a variety of experiments and science projects. Learn basic microbiology skills, or swab different surfaces to determine the relative amounts of...
- MANUFACTURED IN THE USA || The Curated Chemical Collection by Innovating Science is comprised of high-quality chemical products that manufactured in the United States.
- Ready-to-Use Agar Plates for Easy Experiments pre-poured Potato Dextrose Agar (PDA) plates come prepared with nutrient-rich media, allowing you to start your experiments right away without the hassle of preparation.
- Versatile Applications: Perfect for mushroom cultivation, mold detection, food testing, air quality checks, and cosmetic testing.
- Educational & Scientific Use: Ideal for science fairs, classroom experiments, and biology projects to promote hands-on learning.
- Simple and Effective Home Testing Whether you’re a professional or a hobbyist, these plates make testing easy with straightforward handling and optimal performance for accurate results.
- Durable and Reliable for Diverse Uses These plates are robust enough for a variety of uses, from indoor mold detection to monitoring environmental samples, with a user-friendly setup and detailed instructions.
- Our PDA plates feature triple-layer sealed packaging for safe transport. If damaged during shipping, contact us for warranty support.
- EZ BioResearch Pre-poured Malt Extract Agar Plates are the preferred choice for mushroom cultivation. Our MEA agar plates are made with real premium malt extract as an ingredient which ensures their superior quality for mycelium growth. Our...
- EZ BioResearch Pre-poured Malt Extract Agar Plates can be used for a variety of uses such as mold and fungus detection and science fair projects. Students can also use our agar plates because they are safe to use! This is a cool science kit for learning...
- EZ Bioresearch Pre-poured Malt Extract Agar Plates are pre-poured with a thick layer of agar which is good for fungus development. The thick agar surface prevents cracking and drying of the plates. Pre-poured MEA plates are easier to use and much more...
- EZ Bioresearch Pre-poured Malt Extract Agar Plates are made in an industrial manufacturing facility so that you can be sure that the quality of MEA plates is consistent from batch to batch. We offer 100% quality guaranteed. Should you have any problem...
- Fresh & Ready-to-Use: Includes 10 pre-poured LB agar plates in triple-layer resealable packaging to maintain sterility and freshness.
- Complete Testing Kit: Comes with 15 sterile swabs for convenient sample collection and environmental monitoring.
- Premium Quality Composition: LB agar formula includes tryptone, yeast extract, NaCl, and agar for optimal bacterial growth.
- Reliable Growth Performance: Supports clear colony formation of standard bacterial strains such as E. coli and S. aureus at 36±1°C for 24–48 hours.
- Consistent pH & Sterility: pH of 7.0 ± 0.2 at 20–25°C, with each batch tested for sterility and quality control.
What is the purpose of a comparison site?
When you search for a product on the Internet, you can compare all the offers that are available from the sellers. However, it can take time when it is necessary to open all the pages, compare the opinions of the Internet users, the characteristics of the products, the prices of the different models… Offering you reliable comparisons allows us to offer you a certain time saving and a great ease of use. Shopping on the Internet is no longer a chore, but a real pleasure!
We do everything we can to offer you relevant comparisons, based on various criteria and constantly updated. The product you are looking for is probably among these pages. A few clicks will allow you to make a fair and relevant choice. Don’t be disappointed with your purchases made on the Internet and compare the best Life Science Agar Media & Plates now!
Last update on 2026-04-17 / Affiliate links / Images from Amazon Product Advertising API
How to Choose the Best Life Science Agar Media & Plates
Understanding Agar Types
- General Purpose Media: These support the growth of a wide range of non-fastidious organisms. Examples include nutrient agar and tryptic soy agar (TSA), suitable for routine cultivation and quality control.
- Selective Media: These contain inhibitors that prevent the growth of certain microorganisms while allowing others to flourish. They are vital for isolating specific species from mixed cultures, such as MacConkey agar for Gram-negative bacteria.
- Differential Media: These allow for the visual distinction between different types of microorganisms based on their biochemical properties. They often incorporate indicators that change color in response to specific metabolic activities, like mannitol fermentation on Mannitol Salt Agar.
- Enrichment Media: These are designed to increase the numbers of a particular microorganism in a sample, especially when it is present in low concentrations. They provide specific nutrients that favor the target organism's growth.
Considerations for Plates and Media
- Sterility: Ensure all media and plates are sterile to prevent contamination, which can invalidate experimental results. Check for intact packaging and expiration dates.
- Preparation: Decide whether to purchase pre-poured plates for convenience or dehydrated media to prepare in-house. Dehydrated media offers flexibility in volume and concentration but requires sterile preparation techniques.
- Storage: Agar media and plates have specific storage requirements, typically refrigeration, to maintain viability and prevent degradation. Follow manufacturer guidelines for optimal shelf life.
- Application: Match the media type to your specific application, whether it's for basic research, clinical diagnostics, food safety testing, or industrial fermentation.